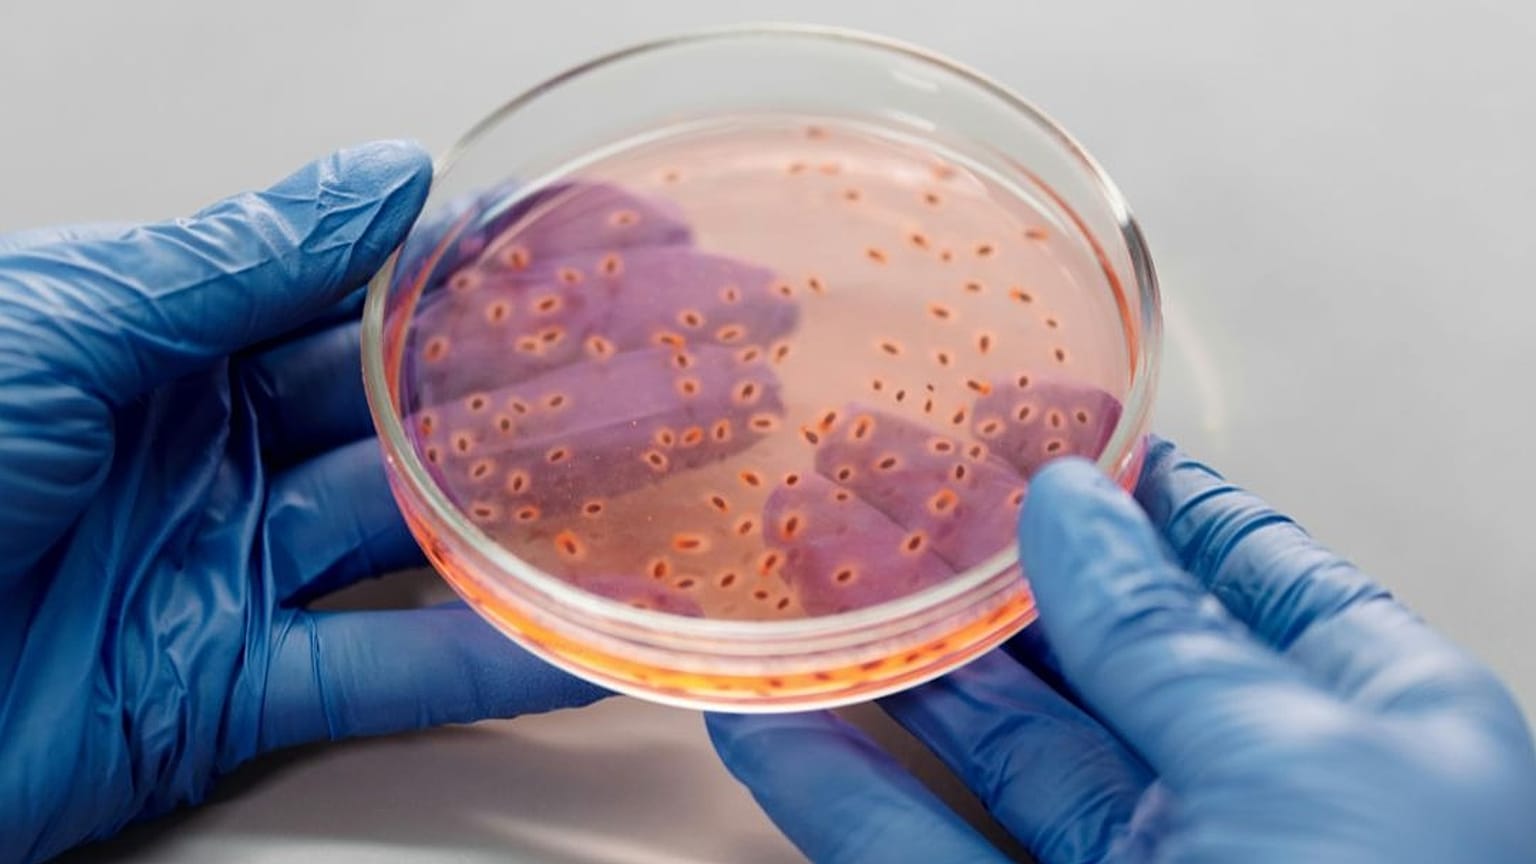

بين طيات الرواسب البحرية والمستنقعات، اكتشف العلماء نوعًا من الكائنات الدقيقة القادرة على تحويل السموم إلى طاقة.
اكتشف فريق من علماء الأحياء الدقيقة شكلًا جديدًا من الأيض الميكروبي، تمكّنت من خلاله بكتيريا تُعرف باسم MISO من "التنفس" عبر معادن الحديد بدلاً من الأوكسجين، مستفيدةً من غاز كبريتيد الهيدروجين السام كمصدر للطاقة.
 اعلان
اعلان
 اعلان
اعلان
نُشرت النتائج في مجلة Nature ضمن مشروع بحثي قاده العالمان مارك موسمان وألكسندر لوي من جامعة فيينا، وقد أظهرت أن هذه البكتيريا قادرة على إزالة السموم من بيئتها وتحويلها إلى مركبات غير ضارة، ما يجعلها عاملًا طبيعيًا في حماية النظم البيئية.
التنفس عبر الحديد
أثبت البحث أن التفاعل بين كبريتيد الهيدروجين ومعادن الحديد الصلبة ليس مجرد تفاعل كيميائي كما كان يُعتقد سابقًا، بل هو عملية بيولوجية بامتياز.
في البيئات الخالية من الأوكسجين، مثل الرواسب البحرية والمستنقعات والمياه الجوفية، تنتج كائنات دقيقة غاز كبريتيد الهيدروجين، وهو غاز سام ذو رائحة شبيهة بالبيض الفاسد. وقد اكتشف الباحثون أن بكتيريا MISO تستغل هذا الغاز لتوليد الطاقة عبر أكسدة الكبريتيد واستخدام أكسيد الحديد الثلاثي (الصدأ)، في عملية تشبه التنفس ولكن بمواد معدنية بدل الأوكسجين.
وقد أدت هذه العملية إلى إزالة السموم من البيئة وإنتاج الكبريتات بدلًا من المركبات الوسيطة، مما يقلّل من تراكم المواد الضارة ويحدّ من توسّع "المناطق الميتة" الخالية من الأوكسجين في البحار والبحيرات.
عملية أسرع من الكيمياء
في المختبر، أظهرت التجارب أن عملية MISO المُحفَّزة إنزيميًا أسرع بكثير من التفاعل الكيميائي التقليدي بين الكبريتيد والحديد، ما يدل على أن الميكروبات هي المحرك الأساسي لهذه التحولات في الطبيعة.
ويقول الباحث سونغ-كان تشين، المؤلف الرئيسي للدراسة، إن أنواعًا مختلفة من البكتيريا تمتلك القدرة الجينية على تنفيذ هذه العملية، وقد تكون مسؤولة عن نحو 7٪ من أكسدة الكبريتيد إلى كبريتات على مستوى العالم، بفضل تدفّق الحديد من الأنهار والأنهار الجليدية إلى المحيطات.
ختامًا، يوضح ألكسندر لوي أن هذا الاكتشاف "يُظهر مدى براعة الأيض الميكروبي في استغلال المواد المحيطة للحفاظ على استمرارية الحياة، ويؤكد أن الكائنات الدقيقة لا تنظف بيئتها فحسب، بل تساعد في إبقاء دورات العناصر الحيوية مستقرة على الكوكب.